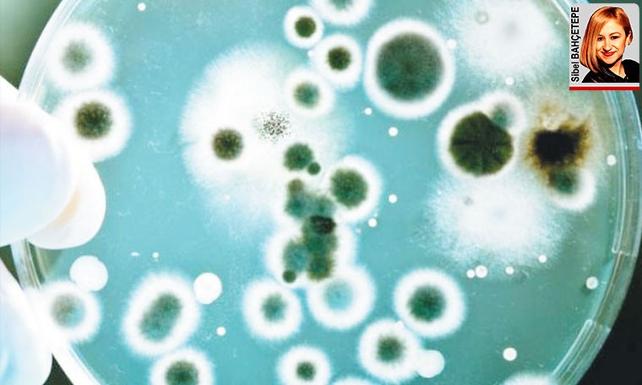

Dünya Sağlık Örgütü’nün (DSÖ) uzun süre hava kirliliğine maruz kalmanın akciğer kanseri riskini belirgin olarak artırdığının da bilindiğini vurgulayan Mirici, özetle şunları dile getirdi: “İklim değişikliği ise özellikle bakteri ve virüs gibi mikroorganizmaların özelliklerini değiştirerek enfeksiyon hastalıklarının artmasına ve şekil değiştirmesine neden olabiliyor.”
Dünya Sağlık Örgütü’nün (DSÖ) uzun süre hava kirliliğine maruz kalmanın akciğer kanseri riskini belirgin olarak artırdığının da bilindiğini vurgulayan Mirici, özetle şunları dile getirdi: “İklim değişikliği ise özellikle bakteri ve virüs gibi mikroorganizmaların özelliklerini değiştirerek enfeksiyon hastalıklarının artmasına ve şekil değiştirmesine neden olabiliyor.”
Prof. Mirici, günümüzde her geçen gün artan çevre sorunlarının başında hava kirliliği ve iklim değişikliğinin geldiğini belirterek, bu durumun akciğer sağlığı açısından tehlikeler oluşturduğunu söyledi.
“Hava kirliliği tüm solunum sistemi hastalıklarının artmasına neden oluyor” diyen Mirici, “Çevresel etkenlerin akciğer sağlığı üzerine etkileri incelendiğinde, hava kirliliği ile hastalıklara bağlı ölüm riskinde artış olduğu; başta astım ve KOAH (Kronik Obstrüktif Akciğer Hastalığı) olmak üzere zatürree ve alerjik hastalıkları hava kirliliğinin artırdığı biliniyor. Hava kirliliği bu hastalıkların oluşmasına neden olmanın yanı sıra var olan hastalıkların gidişatını ve sonucunu olumsuz yönde etkiliyor, acil hastane başvurularının artması gibi sonuçlara da yol açıyor” dedi.
Küresel ısınma bakteri ve virüslerin yapısını farklılaştırıyor
İklim değişikliği ve hava kirliliği sağlık üzerinde olumsuz etkilere neden oluyor. Dünyada her yıl 7 milyon insan hava kirliliğine bağlı nedenlerle erken yaşta hayatını kaybediyor. Dünya Sağlık Örgütü’nün (DSÖ) hava kirliliğini “görünmez katil” olarak tanımladığını hatırlatan Türkiye Solunum Araştırmaları Derneği (TÜSAD) Başkanı Prof. Dr. Arzu Mirici, “Türkiye’de 81 ilimizin ortalama hava kirliliği DSÖ’nün belirlediği değerlere göre kabul edilebilir sınırların üstünde. Bu nedenle, endüstrileşme, sanayileşme ve doğal yaşamın bilinçsiz tahribinin yarattığı hava kirliliğine ve iklim değişikliğine karşı tüm sivil ve resmi kuruluşlar işbirliği yapmalı ve ortak hareket etmeliyiz” dedi.
3.06.2019 22:53:00
Güncellenme:















